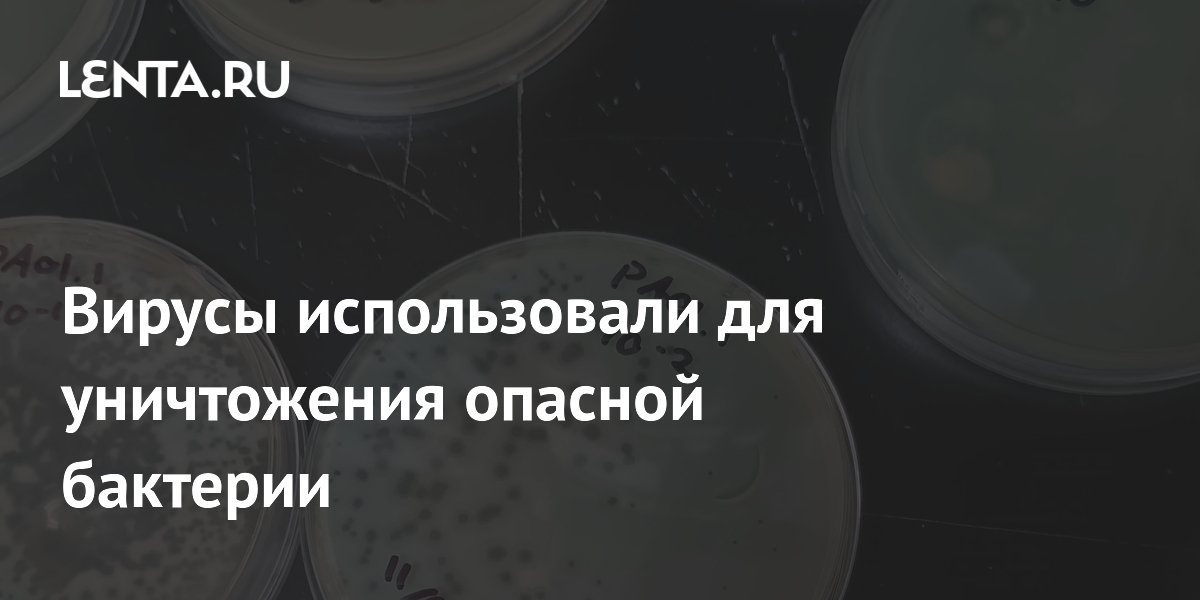

Ядовитые микроорганизмы
Ядовитые микроорганизмы 106 фото
Фестиваль в зарядье сегодня
Телеканалы казахстана программа передач
Единый расчетный центр телефон москва
Как меняются частота и скорость звука
Паджеро 1993 2.5 дизель
Ребенка корд
Московские хроники видео
3 формулы параллельного сопротивления
Сет ночи элден ринг
Передача четыре свадьбы 2026
Гейзер фильтр смарт сменные фильтры
Как успокоить нервы за 1
Как лучше сохранить свеклу на зиму
Luca вышивка наборы
Добрый вечер картинки пожелания четверг
Кто голосует в сентябре
Талреп с трещоткой
Органайзер своими руками с размерами
Кондиционер 14 мощность
Текст песни ром и виски